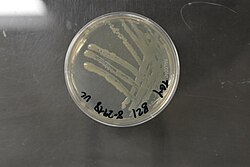

Ethen
| Sicherheitshinweise | |||||||||
|---|---|---|---|---|---|---|---|---|---|
| |||||||||
| MAK | Schweiz: 10000 ml/m3 beziehungsweise 11500 mg/m3[4] | ||||||||
Ethen (auch Äthen, Ethylen oder älter Äthylen) ist eine gasförmige, farblose, hochentzündliche, süßlich riechende organische Verbindung mit der Summenformel C2H4. Es handelt sich um das einfachste Alken, einen ungesättigten Kohlenwasserstoff mit einer Kohlenstoff-Kohlenstoff-Doppelbindung.
Mit einer Jahresproduktion von über 100 Millionen Tonnen ist Ethen die meistproduzierte organische Basischemikalie. Ethen ist ein wichtiger Baustein, der in der chemischen Industrie zur Herstellung einer Vielzahl von Folgeprodukten verwendet wird. Etwa die Hälfte des Ethens wird für die Produktion von Polyethylen und anderen Polyolefinen verwendet. Weitere großtechnisch hergestellte Folgeprodukte sind Ethylenoxid, Styrol, Vinylchlorid, Ethanol oder α-Olefine.
Großwirtschaftlich wird Ethen durch Steamcracken einer Vielzahl von Kohlenwasserstoffen hergestellt. In Europa und Asien wird Ethen hauptsächlich auf Naphtha- oder Gasöl-Basis hergestellt, in den Vereinigten Staaten, Kanada und im Nahen Osten zudem aus Ethan, Propan und Flüssiggas. Andere Verfahren wie das Methanol-to-Olefins-Verfahren oder die Fischer-Tropsch-Synthese bieten die Möglichkeit, Ethen aus Erdgas, Kohle, Erdölprodukten oder Biomasse zu gewinnen. Die Ethenherstellung auf Basis von Bioethanol bietet die Möglichkeit, Ethen aus nachwachsenden Rohstoffen herzustellen. Im Vergleich zum Steamcracken haben diese Verfahren jedoch nur eine untergeordnete Bedeutung.
Ethen ist ein Pflanzenhormon, das viele Aspekte der pflanzlichen Morphogenese reguliert und für die Beschleunigung der Reifung klimakterischer Früchte verantwortlich ist. Bei der Verbrennung fossiler Brennstoffe, bei Waldbränden oder der Verbrennung von Ernterückständen entsteht Ethen, in Städten sind Kraftfahrzeugabgase eine Quelle für Ethen in der Umgebungsluft. Das Einatmen von Ethen in hohen Konzentrationen kann beim Menschen zu Sehstörungen und narkotischen Wirkungen führen. In Gegenwart von Oxidationsmitteln wie Ozon oder Chlor kann Ethen explosiv reagieren.
| Strukturformel | ||
|---|---|---|

| ||
| Allgemeines | ||
| Name | Ethen (IUPAC) | |
| Andere Namen |
| |
| Summenformel | C2H4 | |
| Kurzbeschreibung | hochentzündliches, farbloses Gas mit schwach süßlichem Geruch[1] | |
| Externe Identifikatoren/Datenbanken | ||
| CAS-Nummer | | |
| EG-Nummer | 200-815-3 | |
| ECHA-InfoCard | | |
| PubChem | | |
| Eigenschaften | ||
| Molare Masse | 28,05 g/mol | |
| Aggregatzustand | gasförmig, fluid bei Transport | |
| Dichte | 1,178 kg/m3 (15 °C)[1] | |
| Schmelzpunkt | −169,18 °C[1] | |
| Siedepunkt | −103,8 °C[1] | |
| Dampfdruck | 4,1 MPa (0 °C)[1] | |
| Löslichkeit | sehr schlecht in Wasser (130 mg/l)[1] | |
| Dipolmoment | 0[2] | |
| Thermodynamische Eigenschaften | ||
| ΔHf0 | 52,4 kJ/mol (Gas)[5] | |
Nomenklatur
Die Bezeichnung Ethylen ist in Nordamerika und Europa gebräuchlich, die offizielle IUPAC-Bezeichnung lautet jedoch Ethen. In den IUPAC-Nomenklaturregeln von 1979 wurde der Name Ethylen zunächst belassen, diese Entscheidung wurde jedoch 1993 rückgängig gemacht. In der IUPAC-Nomenklatur ist der Name Ethylen für die Gruppe –CH2CH2– reserviert.[6] Daher sind Bezeichnungen wie Ethylenoxid oder Ethylendibromid zulässig und üblich.
Geschichte
Antike

Im alten Ägypten wurde Ethen unbewusst zum Reifen von Maulbeer-Feigen genutzt. Dazu wurden einige Feigen angeritzt, um einen ganzen Strauch reifen zu lassen.[7] Im alten China wurden Räucherstäbchen, die beim Verbrennen geringe Mengen Ethen freisetzen, in einem Lagerraum für Birnen abgebrannt, um die Früchte reifen zu lassen.[8]
Möglicherweise war Ethen Bestandteil eines Gasgemisches aus Kohlenwasserstoffen und Kohlenstoffdioxid, das im Adyton des Apollon-Tempels in Delphi austrat und die Pythia in Trance versetzte, die daraufhin die Orakelsprüche des Gottes verkündete.[9] Dies wurde bereits von Cicero beschrieben, der in seinem Werk De divinatione (Über die Weissagung) auf die Existenz dieser Gase hinwies: „Im Übrigen meine ich, dass es auch gewisse Ausdünstungen der Erde gab, die in den Geist eindrangen, so dass er Orakel ausstieß.“[10] Das Erwachen aus der Trance soll schnell erfolgt sein, und außer dem Gefühl, vom Gott Apollon besessen zu sein, hatte Pythia keine Erinnerung an die Ereignisse während der Trance. Diese Wirkungen ähneln denen, die von Toxikologen für Patienten unter leichter Ethen-Narkose beschrieben wurden.[9]
Frühe Arbeiten

Die erste Erwähnung von Ethen als Gas findet sich im Jahr 1669 in dem Werk Actorum Laboratorii Chymici Monacensis, seu Physicae subterraneae des deutschen Alchemisten Johann Joachim Becher. Becher erhielt das Gas durch Erhitzen von Ethanol mit Schwefelsäure.[11] Bereits 1777 soll der niederländische Mediziner Jan Ingenhousz von der in Amsterdam erfolgten Synthese von Ethen durch Henricus Aeneae (Enée) und dessen Mitarbeiter John Cuthbertson erfahren haben.[12][13]
Im Jahr 1795 wurde von den niederländischen Chemikern Johan Rudolph Deiman, Adriaan Paets van Troostwijk, Anthonie Lauwerenburgh und Nicolaas Bondt die Synthese von 1,2-Dichlorethan aus Ethen und Chlor entdeckt. Da das Produkt als Öl der holländischen Chemiker bezeichnet wurde, wurde das 1669 von Becker entdeckte und 1799 von oseph Priestley untersuchte Ethen (im Deutschen ursprünglich Äthylen) im Französischen gaz oléfiant („ölbildendes Gas“), im Englischen olefiant gas, genannt.[14] 1807 versuchte John Dalton eine Strukturformel aufzustellen.[15] In der zweiten Hälfte des 19. Jahrhunderts gelang die synthetische Darstellung pflanzlicher Säuren wie zum Beispiel der Bernsteinsäure aus Ethen.[16]
Auf die anästhetischen Eigenschaften von Ethen hatte 1864 der Physiologe Ludimar Hermann hingewiesen.[17] Das Gas war als Anästhetikum neben Lachgas vor allem bei schwachen Betäubungen in Gebrauch. Es wirkt narkotisch und muskelentspannend. Im Jahr 1923 wurde es in Chicago zum ersten Mal öffentlich benutzt, die narkotische Wirkung des Ethens ist etwas stärker als die des Lachgases und hat einen ähnlichen Wirkmechanismus. Nach der 1923 erschienenen Publikation von A. Luckhardt und J. B. Carter von der University of Chicago über Narkosen mit Ethen bei über 100 Operationen fand es zunächst vermehrt Anwendung.[17][18][19] Später wurde es jedoch nicht mehr verwendet, da es brennbar und in Verbindung mit Sauerstoff hoch explosiv ist und unangenehm riecht. Außerdem war die Narkosewirkung des Ethens im Vergleich zu anderen gebräuchlichen Narkosemitteln nicht sehr gut; um eine gute Wirkung zu erzielen, musste das Narkosegemisch etwa 90 % Ethen enthalten.[20]
Entdeckung der Reifewirkung

Ende des 19. Jahrhunderts studierte der russische Biologe Dimitri Nelyubov die Reaktion der Erbse auf Leuchtgas. Dabei entdeckte er, dass das im Leuchtgas enthaltene Ethen der Bestandteil war, auf den die Erbsen reagierten. Der Wissenschaftler Frank Denny vom Landwirtschaftsministerium der Vereinigten Staaten erkannte, dass die unter Landwirten verbreitete Praxis, Zitrusfrüchte in Schuppen unter Kerosinbeleuchtung reifen zu lassen, ebenfalls auf das bei der Verbrennung von Kerosin in Spuren entstehende Ethen zurückzuführen ist.[8] Er hatte festgestellt, dass die Kerosinabgase unwirksam wurden, wenn sie durch eine Bromwasserlösung geleitet wurden, wobei das Ethen zu 1,2-Dibromethan reagiert.
Nach der Entdeckung der reifungsfördernden Wirkung von Ethen bei Zitrusfrüchten wurde es bald bei anderen Früchten eingesetzt. Da reife Bananen wegen ihrer Empfindlichkeit nicht aus den Tropen zu den Märkten in Europa und den USA transportiert werden konnten, war es üblich, grüne Bananen zu verschiffen. Diese wurden am Bestimmungsort zunächst mit Hilfe von Kerosinöfen nachgereift. Da die Ethenreifung bei niedrigeren Temperaturen erfolgt und dadurch weniger Fäulnis auftritt, wurde die Kerosinreifung bald verdrängt. Das Verfahren wurde schließlich für die Reifung von Tomaten, Ananas, Melonen, Birnen Mangos, Paprika, Avocados, Äpfeln, Pflaumen und vielen anderen Früchten eingesetzt.[21]
In den 1930er Jahren entdeckte Richard Gane, dass Pflanzen Ethen synthetisieren, und er bewies, dass Ethen ein endogenes Pflanzenhormon ist. Von den 1960er bis zu den frühen 1980er Jahren wurde die Ethen-Biosynthese in Pflanzen aufgeklärt und membrangebundene Ethenbindungsstellen entdeckt und charakterisiert. In den 1990er Jahren begann die Aufklärung des Wirkungsmechanismus.[22]
Technische Herstellung

Technisch wurde Ethen zunächst durch Dehydratisierung von Ethanol oder durch Isolierung aus Kokereigas gewonnen. Eine erste großtechnische Herstellung von Ethen aus Ethanol erfolgte 1913 in den Elektrochemischen Werken in Bitterfeld.[23] Das so gewonnene Ethen wurde zu Kühlzwecken benutzt. Die Firma Imperial Chemical Industries entdeckte 1933 in Laborversuchen die Hochdruckpolymerisation von Ethen. Nach der Patenterteilung 1937 begann 1938 der Bau der ersten Polyethylenanlage in Großbritannien. In den Vereinigten Staaten begann die industrielle Produktion 1943 durch DuPont.[24] Mit der Möglichkeit, Polyethylen durch Hochdruckpolymerisation herzustellen, stieg die Nachfrage nach Ethen sprunghaft an.
Der deutsche Inlandsbedarf an Ethen, der 1944 bei 200.000 Tonnen pro Jahr lag, stieg in der Nachkriegszeit rasch an. Als Rohstoff für eine Vielzahl von Produkten, darunter Glycole, Polyglycole, Ethylenoxid und Ethanol, gewann Ethen schnell an Bedeutung. Diese Entwicklung wurde durch die Entdeckung der Niederdruckpolyethylensynthese durch Karl Ziegler Anfang der 1950er Jahre noch verstärkt.[25] In den ersten Nachkriegsjahren standen für die Produktion die Teilhydrierung von Ethin, das über die Carbidroute aus Kohle und Kalk hergestellt wurde, die Dehydratisierung von Ethanol und die Abtrennung aus Kokerei- und Crackgasen durch Verflüssigung zur Verfügung. In Frankreich wurde ein Verfahren angewandt, bei dem Kokereigase durch eine Schwefelsäurelösung geleitet wurden. Das Ethen wurde dabei als Schwefelsäureester abgefangen und durch Hydrolyse zu Ethanol freigesetzt.[26]
Das technisch relevante Verfahren ist das Steamcracken von Naphtha oder höheren Kohlenwasserstoffgemischen wie Hydrowax. Während in den Vereinigten Staaten die Ethenproduktion 1950 noch bei 675.000 Tonnen lag, stieg sie bis 1962 bereits auf etwa 1.800.000 Tonnen.[27]

Aufgrund des steigenden Bedarfs wurde in den 1960er Jahren eine Ethen-Pipeline konzipiert, die Ethen zwischen den Herstellern und Verbrauchern in den Niederlanden, Belgien und Deutschland transportiert. Aus Gründen der Wirtschaftlichkeit und der Sicherheit wird Ethen grundsätzlich nur per Pipeline transportiert. In Deutschland und Teilen der Niederlande und Belgiens wurde 1974 die Ethylene-Pipeline ARG zum Transport von Ethen zwischen den Chemiestandorten von Rotterdam über Antwerpen in den Raum Köln und in die Emscher-Lippe-Region sowie in das Rhein-Main-Gebiet und nach Ludwigshafen am Rhein in Betrieb genommen. Die Ethylene-Pipeline ARG hat eine Länge von etwa 500 Kilometern und transportiert jährlich bis 2,0 Millionen Tonnen Ethen zu etwa 20 direkt angeschlossenen petrochemischen Unternehmen.[28]
In Bayern verbindet die Ethylen-Pipeline Münchsmünster-Gendorf das Bayrische Chemiedreieck im Südosten mit dem Chemiestandort bei Ingolstadt. Nach einer sechsjährigen Bauzeit wurde 2013 die 370 Kilometer lange Ethylen-Pipeline Süd von Münchsmünster nach Ludwigshafen am Rhein in Betrieb genommen, eines der größten Infrastrukturprojekte der deutschen chemischen Industrie im 21. Jahrhundert. Sie verbindet das nordwest-deutsche Netz mit den bayerischen Chemiestandorten.[29] Sie verläuft von Münchsmünster weitgehend in westlicher Richtung entlang der Transalpinen Ölleitung, quert den Rhein bei Karlsruhe und führt dann nach Norden bis Ludwigshafen. Die Ethylen-Pipeline Süd hat eine Kapazität von 400.000 Tonnen Ethen pro Jahr und kann sowohl von Münchsmünster nach Ludwigshafen als auch in umgekehrter Richtung pumpen.[30]
Neuere Entwicklungen

Erst 1981 wurde der Prozess der Dehydratisierung von Ethanol in Brasilien von Salgema Indústrias Químicas wieder aufgenommen. Salgema produzierte etwa 100.000 Tonnen pro Jahr, basierend auf einem Patent der Petrobras. Ausgangsmaterial für das „Green Ethylene“ ist Ethanol aus Zuckerrohr. Im Jahr 2010 errichtete die Braskem ein Werk zur Dehydratisierung von Ethanol in Triunfo in Rio Grande do Sul mit einer Jahreskapazität von 200.000 Tonnen.[23]
Ab den 1990er Jahren wurde billiges Ethan aus Erdgas, das durch Fracking gewonnen wurde, zum neuen Ausgangsstoff für die Ethenproduktion in den USA. Dies veranlasste die US-amerikanischen Chemieproduzenten zum Bau neuer Ethancracker-Kapazitäten. Allein zwischen 2017 und 2020 wurden rund 10 Millionen Tonnen zusätzliche Kapazität installiert.[31]
Im Jahr 2010 wurden weltweit etwa 123 Millionen Tonnen an Ethen hergestellt.[32] Das Produktionsvolumen in Deutschland lag zwischen 2013 und 2022 bei 4,32 bis 5,2 Millionen Tonnen.[33] Der weltweite Ethenmarkt hatte 2022 ein Volumen von rund 137 Milliarden US-Dollar.[34] Der Ethan-Steamcracker TX-9 der Dow in Oyster Creek, Texas, besitzt eine Nennkapazität von Millionen Tonnen Ethen pro Jahr und war damit 2020 die größte Ethen-produzierende Anlage der Welt.[35] In den Jahren nach der weltweiten COVID-19-Pandemie konnten die US-Hersteller ihren Wettbewerbsvorteil der niedrigen Rohstoffkosten weiter ausbauen. Andererseits belasteten die Inflation und die Energiekostenproblematik die Rentabilität der Herstellung von Ethen und seinen Folgeprodukten im europäischen Raum.[36]
Vorkommen
Die Ethenkonzentration in der Atmosphäre wird weltweit überwiegend von natürlichen Quellen verursacht und liegt in der globalen Troposphäre, der untersten Schicht der Erdatmosphäre, meist unter 0,1 parts per billion (ppb).[37] Ein kleiner Teil des Ethens gelangt in die Stratosphäre. Die Ethenproduktion erfolgt hauptsächlich biotisch durch höhere und niedere Pflanzen sowie durch mikrobiologische Aktivitäten, etwa Bakterien der Gattung Pseudomonas oder Schimmelpilze der Gattung Mucor. Abiotisch entsteht Ethen beispielsweise durch den nicht-enzymatischen Abbau von Ethionin, Eisen(II)-Ionen katalysieren die abiotische Bildung von Ethen aus Methionin. In der Landwirtschaft werden zum Teil Dünger mit Ethen freisetzenden Substanzen wie 2-Chlorethylphosphonsäure eingesetzt.[38] Ethen entsteht ebenfalls bei Waldbränden oder Brandrodungen.
Lokale Ethenemittenten, von denen im Jahr 2022 weltweit 336 identifiziert wurden, sind in der chemischen und petrochemischen Industrie, der Kohleförderung und -verarbeitung, der Metallurgie sowie in einigen städtischen Gebieten zu finden. Die höchste Dichte an lokalen Ethenemittenten findet sich in Europa, Russland, dem Nahen Osten, Indien und Ostasien.[37] Der Autoverkehr trägt in städtischen Gebieten zur Ethenbelastung bei.
Ethen wird in der Atmosphäre schnell abgebaut, aber es trägt als Vorläufersubstanz von Formaldehyd und bodennahem Ozon zur Luftverschmutzung bei. Die Verweilzeit von Ethen in der Atmosphäre hängt von der Konzentration der Hydroxyl-Radikale und des Ozons ab und beträgt im Mittel 24 bis 34 Stunden. In industriellen oder städtischen Gebieten mit örtlich höheren Konzentrationen von Hydroxyl-Radikalen und Ozon kann die Verweilzeit kürzer sein.[37]
Ethen ist ein Produkt der Methan-Chemie in den Atmosphären der äußeren Planeten. Es wurde unter anderem in den Atmosphären des Jupiters, des Saturns und des Neptuns nachgewiesen.[39][40][41] Auch auf Makemake, einem Zwergplaneten und einem der größten bisher bekannten Objekte im Kuipergürtel, wurde Ethen nachgewiesen. Das Ethen liegt dort in fester Form als Etheneis vor, dass wahrscheinlich auf strahlenchemischen Weg aus Methan entstanden ist.[42]
Herstellung
Ethen fällt teilweise als Kuppelprodukt an und kann durch Isolierung aus zwangsläufig anfallenden Gemischen von gasförmigen Paraffinen und Olefinen oder durch gezielte Verfahren zur Ethenherstellung gewonnen werden. Ethen fällt beispielsweise als Nebenprodukt in Raffinerie- und Kokereigasen, bei der Fischer-Tropsch-Synthese mit Eisenkatalysatoren und bei der Acetylenherstellung an. Zu den direkten Verfahren gehören das Steamcracken, die Dehydrierung von Ethan, verschiedene Pyrolyseverfahren, die Teilhydrierung von Acetylen, die Dehydrierung von Ethanol und andere Verfahren. Im Jahr 2016 wurden etwa 97 % des Ethens durch Steamcracken hergestellt.[43] Die weltweiten Produktionskapazitäten beliefen sich im Jahr 2019 auf 187 Millionen Tonnen bei einem Bedarf von 164 Millionen Tonnen. Damit war Ethen vor Propen und Benzol die meistproduzierte organische Basischemikalie.[44][45]
Steamcracken
.svg.png)
Der größte Teil des benötigten Ethens wird durch Steamcracken von Kohlenwasserstoffen gewonnen. Als Rohstoffe werden meist Ethan, Erdgas, Naphtha oder höhersiedende Destillatschnitte von Erdöl verwendet, die mit Wasserdampf auf hohe Temperaturen erhitzt werden. Der Wasserdampf dient als Wärmeträger und reduziert die Koksbildung in den Cracköfen. Die Dampfeinspritzung senkt außerdem den Partialdruck der entstehenden Olefine und vermindert dadurch Sekundärreaktionen wie die Polymerisation.[46]
Obwohl es verschiedene Arten von Crackern gibt, besteht der wesentliche Verfahrensschritt darin, Kohlenwasserstoffe und Wasserdampf bei Temperaturen von 800 bis 900 °C in einen Crackofen einzuspritzen, wobei die Temperaturen für das Cracken von Ethan höher sind als für schwerere Rohstoffe. Die Verweilzeit liegt im Bereich von einer Sekunde oder darunter.[46]
Die Verteilung der entstehenden Produkte hängt neben den Crackbedingungen von den eingesetzten Rohstoffen ab, wobei leichtere Rohstoffe einen höheren Anteil an Ethen liefern. Das Steamcracken von Ethan liefert eine Ausbeute von bis zu 76 % Ethen, während die Ausbeute bei Naphtha bei etwa 31 % liegt.[47]
Das Steamcracken ist ein energieintensiver Prozess, der jährlich etwa 40 % des gesamten Energieeinsatzes der petrochemischen Industrie erfordert.[48] Pro Tonne produziertem Ethen entstehen beim Steamcracken etwa 1,5 Tonnen Kohlenstoffdioxid, was im Jahr 2020 zu einem Ausstoß von etwa 260 Millionen Tonnen Kohlenstoffdioxid beim Steamcracken führte. Dieser Wert entsprach etwa 0,8 % der weltweiten Kohlenstoffdioxidemissionen 2020, die auf 34 Milliarden Tonnen geschätzt wurden.[49]
Dehydratisierung von Ethanol

Die Dehydratisierung von Ethanol spielt in Ländern mit einer großen Bioethanolproduktion wie Brasilien eine wichtige Rolle. Dort begann in den 1970er Jahren ein Programm zur Herstellung von Ethanol aus Zuckerrohr, um die Abhängigkeit von Erdölimporten zu verringern. Die Anbaufläche für Zuckerrohr belief sich 2007 auf rund 7,8 Millionen Hektar, von denen etwa die Hälfte für die Herstellung von Bioethanol genutzt wird.[50]
Die Dehydratisierung erfolgt sowohl intramolekular unter Bildung von Ethen als auch intermolekular und Bildung von Diethylether. Diethylether kann in einem zweiten Schritt weiter zu zwei Molekülen Ethen dehydratisiert werden. Beide Reaktionen sind endotherm.[50]
ΔH298 K = 45,3 Jmol−1
Ältere Anlagen nutzten auf Trägern fixierte Phosphorsäure als Katalysator. Diese Katalysatoren lieferten Produkte hoher Reinheit, waren jedoch korrosiv und nur wenig aktiv. Neuere Anlagen nutzen Katalysatoren auf Basis von Aluminiumoxid und Kieselsäure. Dabei wird Ethanol gasförmig über die Katalysatoren geleitet, die Reaktion findet in einem Temperaturbereich von 350 bis 500 °C statt, wobei eine Ethenselektivität von etwa 97 bis 99 % erreicht wird.[50]
Die Ethenherstellung auf Basis von Bioethanol ist dem konventionellen Steamcracking aus ökologischer Sicht überlegen. Durch den Einsatz nachwachsender Rohstoffe, niedrigere Prozesstemperaturen bei der Dehydratisierung von Ethanol und eine höhere Selektivität entstehen insgesamt weniger Schadstoffe.[51]
Methanol-to-Olefins
Mobil entwickelte Anfang der 1970er Jahre ein Verfahren, bei dem Erdgas zunächst in Synthesegas und anschließend in Methanol umgewandelt wird. Das Methanol reagiert in Gegenwart eines Zeolithkatalysators zu Olefinen. Im ersten Schritt wird Methanol zu Dimethylether dehydratisiert, der durch weitere Dehydratisierung zu Ethen reagiert.
Der Zeolithkatalysator ZSM-5 ist ein in der Industrie häufig verwendeter Katalysator für das Methanol-to-Olefins-Verfahren (MTO). Beim Einsatz dieses Katalysators entsteht jedoch eine breite Palette von Produkten, darunter Aromaten und Paraffine. Der von Union Carbide in den 1980er Jahren entwickelte Siliziumaluminiumphosphatkatalysator SAPO-34 weist dagegen eine höhere Selektivität für Olefine auf und wird bevorzugt eingesetzt, wenn diese das Zielprodukt der Reaktion sind. SAPO-34 besitzt eine Käfigstruktur, während ZSM-5 eine Kanalstruktur aufweist. Typische Reaktionsbedingungen liegen bei einer Temperatur von 500 °C und einem Druck von 2,2 bis 3,5 bar.[47]
Fischer-Tropsch-Synthese

Es gibt zwei Möglichkeiten, Ethen durch die Fischer-Tropsch-Synthese herzustellen. Zum einen kann Ethen in höheren Konzentrationen direkt in der Fischer-Tropsch-Synthese bei hohen Temperaturen in Wirbelschichtreaktoren hergestellt werden. Dabei werden niedermolekulare Olefine und Benzin hergestellt. Die bestehenden Hochtemperatur-Synthol-Fischer-Tropsch-Anlagen von Sasol produzieren große Mengen Ethen, Ethan und Propen. Zur Gewinnung von Ethen wurden Ethen-Rückgewinnungsanlagen installiert, die Produktion wurde durch eine Erhöhung der Ethan-Cracker-Kapazität weiter gesteigert. Weiterhin kann das erzeugte Benzin als Einsatzstoff für Steamcracker verwendet werden. Dadurch kann eine hohe Ausbeute an Ethen erzielt werden.[52]
Fluid Catalytic Cracking
Fluid Catalytic Cracking (FCC) ist ein Konversionsverfahren, das eingesetzt wird, um aus hochsiedenden Kohlenwasserstofffraktionen des Erdöls Benzin, Olefine und andere Produkte herzustellen. Das Zielproduct des Fluid Catalytic Cracking sind Motorenbenzine, Ethen fällt dabei in prozentual geringen Mengen als Nebenprodukt an.[51]
Oxidative Kupplung von Methan
Ethen kann durch die heterogenkatalytische oxidative Kopplung von Methan hergestellt werden.[53] Bei dieser Reaktion reagiert Methan zunächst oxidativ zu Ethan und danach weiter zu Ethen.[54]
Dabei entsteht Ethan durch die Kopplung von Methylradikalen in der Gasphase. Die Methylradikale entstehen an katalytisch aktiven Stellen an der Oberfläche des heterogenen Katalysators. Möglicherweise handelt es sich dabei um reaktive Sauerstoffionen. Der Umsatz beträgt etwa 20 %, wobei eine Selektivität zu Ethan und Ethen von 80 % erreicht wird. Die Reaktion findet bei einer Temperatur von 700 bis 800 °C statt. Als Nebenprodukte fallen Wasserstoff, Wasser, Kohlenstoffdioxid und -monoxid sowie Propan, Propen und Ethin an.[55]
Metathese von Propen
Bei der Metathese von Propen entstehen Ethen und 2-Buten.
Diese Technologie wurde bisher in einer Anlage im kanadischen Shawinigan und an der Golfküste der USA eingesetzt. Da die Propenproduktion in Ethan-Crackern die Nachfrage nach Propen nicht decken kann, hat die umgekehrte Reaktion, die Metathese zur Herstellung von Propen aus Ethen und 2-Buten, an Bedeutung gewonnen.[56]
Partielle Hydrierung von Ethin

Beim Cracken von Naphtha zur Herstellung von Ethen fällt in geringen Mengen Ethin an, das bei der Polyethylenherstellung die Ziegler-Katalysatoren vergiftet. Um dies zu vermeiden, muss das Ethin partiell zu Ethen hydriert werden.[57] Vor dem Aufkommen des Steamcrackens als Hauptroute zu Ethen war die partielle Hydrierung von Ethin aus Calciumcarbid in Deutschland ein gängiges technisches Verfahren, mit dem etwa die Hälfte des Ethenbedarfs gedeckt wurde.[58]
Zur Herstellung von Ethen aus Ethin wird ein Gemisch aus Wasserstoff, Ethin und Wasserdampf über einen heterogenen Kieselgel-Palladium-Katalysator geleitet, dessen Palladiumkonzentration etwa 0,01 % beträgt. Die Reaktion bei etwa 200 °C wird im Wasserstoffüberschuss gefahren und je nach Katalysatoraktivität so gesteuert, dass die Restethinmenge unter 1 % liegt. Die Standzeit des Katalysators beträgt etwa ein Jahr, die Deaktivierung erfolgt durch Ablagerung von Ethinpolymerisaten auf der Katalysatoroberfläche. Der Katalysator wird bei 600 °C mit einem Luft-Wasserdampf-Gemisch regeneriert.[58]
Katalytische nicht-oxidative Dehydrierung von Ethan
Neben dem Cracken ist die Dehydrierung von Ethan, das in großen Mengen in Schiefergasen vorkommt, eine technisch mögliche Route. Die katalytische nicht-oxidative Dehydrierung von Ethan zu Ethen mit Platin- und Chromkatalysatoren wurde eingehend untersucht. Die Reaktion ist in hohem Maße endotherm und gegenüber dem Steamcracken nicht konkurrenzfähig.[59]
ΔH298 K = 136 kJmol−1
Eigenschaften
Moleküleigenschaften


Ethen ist ein planares Molekül mit einer Doppelbindung. Aufgrund der sp2-Hybridisierung der Kohlenstoffatome ist das Molekül planar, das heißt, alle Atome liegen in einer Ebene. Ethen besitzt die Punktgruppe D2h.[60]
Die H-C-H-Bindungswinkel betragen je 117° und weichen damit nur leicht vom theoretisch idealen Wert der trigonal planaren Form mit 120° ab. Die C=C-Doppelbindung ist mit einer Bindungslänge von 134 Picometern deutlich kürzer als die C-C-Einfachbindung in Ethan mit 154 Picometern.[61]
Die Bindungen zwischen den Kohlenstoffatomen in Ethen sind jedoch nicht gleich stark. Die Bindungsenergie der Kohlenstoff-Kohlenstoff-Doppelbindung beträgt 611 Kilojoule pro Mol und damit weniger als das Doppelte der Kohlenstoff-Kohlenstoff-Einfachbindung im Ethan, die etwa 347 Kilojoule pro Mol beträgt.[62][63] Allgemein ist Ethen aufgrund der hohen Elektronendichte zwischen den beiden Kohlenstoff-Atomen wesentlich reaktiver als zum Beispiel das einfach gebundene Ethan.
Physikalische Eigenschaften
Auf Grund der reaktiven C=C-Doppelbindung ist die Addition an diese Bindung eine typische Reaktion des Ethens. In Wasser sind nur 130 mg/l Ethen löslich, in organischen (unpolaren) Lösungsmitteln ist Ethen jedoch gut löslich. Ethen hat einen leicht süßlichen, unangenehmen Geruch. Die Geruchsschwelle liegt bei 260 ml/m3. Der Heizwert von Ethen beträgt 58,9 MJm−3.[64]
Weitere Eigenschaften:
- Molare Schmelzenthalpie:
3,35 kJ/mol[62]
- Molare Verdampfungsenthalpie:
13,55 kJ/mol[62]
- Molare Wärmekapazität:
42,9 J/(mol·K)[62]
- Molare Standardbildungsenthalpie:
52,32 kJ/mol[61]
- Molare Standardbildungsentropie:
220 J/(mol·K)[61]
Ethen kristallisiert bei −175 °C in einer rhombischen Elementarzelle mit zwei Molekülen pro Zelle und den Gitterparametern a = 6,46 Å, b = 4,87 Å, c = 4,14 Å. Die Dichte beträgt 0,717 g/cm3.[65]
Der Flammpunkt liegt bei −136 °C, der Zündpunkt bei 425 °C.[66]
Chemische Eigenschaften
Elektrophile Addition
Verschiedene Stoffklassen wie Halogene, Halogenwasserstoffe oder Wasser reagieren mit Ethen in einer Elektrophilen Addition. Dabei wird die π-Bindung unter Bildung von zwei neuen σ-Bindungen gespalten. Die Reaktion wird durch den Angriff eines Elektrophils X+ an der Kohlenstoff-Kohlenstoff-Doppelbindung ausgelöst. Die positive Ladung oder Partialladung des Elektrophils wird auf die Kohlenstoff-Kohlenstoff-Bindung übertragen und es entsteht unter Bildung einer Elektrophil-Kohlenstoff-Bindung ein Carbokation. Im zweiten Schritt reagiert das Carbokation mit einer elektronenreichen Spezies Y− und bildet eine weitere kovalente Bindung.[67]
Beim Einsatz von Halogenen entstehen 1,2-Dihalogenethane, beim Einsatz von Halogenwasserstoffen monosubstituierte Halogenalkane. In der sauer katalysierten Reaktion mit Wasser entsteht Ethanol.
Freie Radikaladdition
Die freie Radikaladdition beginnt mit dem Zerfall eines Radikalstarters in zwei freie Radikale oder mit einer strahlen- oder photochemisch initiierten Radikalbildung. Die freien Radikale lagern sich im nächsten Schritt an die Doppelbindung des Ethens an, wobei ein um eine Etheneinheit verlängertes Radikal entsteht. An dieses Radikal können sich weitere Ethenmoleküle anlagern, so dass durch radikalische Kettenpolymerisation lineare und verzweigte Polymere entstehen können. Durch die Kombination zweier Radikale kommt es zu einer Abbruchreaktion.[68]
Pericyclische Reaktionen
Ethen reagiert in einer En-Reaktion, einer pericyclische Reaktion mit einer Verbindung, die Wasserstoff in allylischer Position aufweist, etwa Propen.[69]
Dies geschieht unter Bindungsbildung zwischen einem Kohlenstoffatom der Doppelbindung und dem Enophil unter Übertrag des allylischen Wasserstoffs auf das Enophil.
Mit 1,3-Butadien reagiert Ethen als Dienophil in einer Diels-Alder-Reaktion zu Cyclohexen.[70]
Metallorganische Reaktionen
Von dem dänischen Chemiker William Christopher Zeise wurde 1830 die erste metallorganische Verbindung mit einem Ethen-Liganden, das Zeise-Salz mit der Summenformel K[PtCl3(C2H4)]H2O, synthetisiert.[71]
Mit Übergangsmetallen bildet Ethen π-Komplexe, mit Nickel zum Beispiel bildet Ethen den Komplex Tris-(ethen)-nickel(0).[72] Bei dem Komplex handelte es sich um den ersten binären Metall-Ethen-Komplex. Ethen lässt sich etwa durch Substitutionsreaktionen oder durch reduktive Spaltung in Metallkomplexe einführen.
Die Bindungsverhältnisse in metallorganischen Ethenkomplexen lassen sich durch das Dewar-Chatt-Duncanson-Modell beschreiben.
Dabei erfolgt die Hinbindung über eine σ-Donor-Bindung aus dem besetzten π-Orbital des Ethens in ein d-Orbital des Metalls und die Rückbindung über eine π-Donor-Bindung aus einem besetzten d-Orbital in die antibindenden π*-Orbitale des Ethens. Beide Effekte führen zu einer Verlängerung der Kohlenstoff-Kohlenstoff-Bindung gegenüber dem freien Ethen und gegebenenfalls zum Verlust der planaren Ethenstruktur. Je nach Stärke der Bindungen können ein planarer Metall-Ethen-π-Komplex oder ein Metallacyclopropan als Grenzfälle betrachtet werden.
Durch photochemische oder thermische Anregung kann es zu einer Umlagerung eines Ethen-Komplexes in einen Vinylhydrid-Komplex kommen.[73]
Die Bildung eines Ethen-π-Komplexes ist der erste Schritt in vielen homogenkatalytischen Reaktionen wie der Hydroformylierung. Nach der Bildung der aktiven Katalysatorspezies durch den Verlust eines Kohlenstoffmonoxidliganden erfolgt die Komplexierung des 16-Elektronen-Hydridocobaltcarbonylkomplex mit Ethen zu einem 18-Elektronenkomplex. Anschließend erfolgt die Insertion des Ethens in die Wasserstoff-Cobalt-Bindung unter Bildung eines 16-Elektronen-Alkylkomplexes. Dieser Alkylkomplex nimmt einen weiteren Kohlenstoffmonoxidliganden auf. Durch Insertion eines Kohlenstoffmonoxid-Liganden in die Metall-Alkyl-Bindung entsteht ein Acylkomplex. Durch oxidative Addition von molekularem Wasserstoff und Freisetzung von Propionaldehyd entsteht schließlich wieder der 16-Elektronen-Ausgangskomplex. Die Hydroformylierung von Ethen mit Kohlenstoffmonoxid und Wasserstoff ist ein technischer Weg zur Darstellung von Propionaldehyd (R = H).[74]
Dieser sogenannte Heck-Breslow-Mechanismus der Cobalt-katalysierten Hydroformylierung wurde 1960 vom späteren Nobelpreisträger Richard F. Heck und von David Breslow aufgeklärt.[75]
Durch Addition mit Formaldehyd reagiert Propionaldehyd zu Trimethylolethan, einem Zwischenprodukt für die Herstellung von Alkydharzen. Proprionaldehyd wird weiterhin zur Synthese von Aromastoffen wie 3-(p-Cumenyl)-2-methylpropionaldehyd und 2-(4-tert-Butylbenzyl)propionaldehyd verwendet.
Durch Nickelkatalysatoren wird die Hydrocyanierung von Ethen mit Cyanwasserstoff zu Propionitril katalysiert (R = H).[76]
Durch Hydrierung entsteht Propylami, durch säurekatalysierte Hydrolyse Propionsäure.
Propylamin wird zum Beispiel zur Synthese von Fungiziden wie Prochloraz eingesetzt. Propionsäure wird neben vielfältigen Verwendungen in der chemischen Industrie als Konservierungsmittel sowohl in Futtermitteln als auch in Lebensmitteln verwendet. Auf diese Anwendung entfällt etwa die Hälfte der weltweiten Propionsäureproduktion.
Oxidation

Ethen verbrennt bei ausreichender Sauerstoffzufuhr zu Wasser und Kohlenstoffdioxid.
Bei 25 °C und 1,01325 bar beträgt die Verbrennungsenthalpie −1411 Kilojoule pro Mol.[77] Ethen wird als möglicher Treibstoff für Staustrahltriebwerke, so genannte Scramjets, mit Überschallverbrennung untersucht. Mit einem Scramjet-Triebwerk können Flugzeuge Überschallgeschwindigkeit erreichen, was einen schnellen globalen Verkehr und einen kostengünstigen Zugang zum Weltraum ermöglichen kann.[78]
Hydrierung
Ethen lässt sich mit Wasserstoff unter hohem Druck und in Anwesenheit metallischer Katalysatoren wie Platin, Palladium und Nickel zu Ethan hydrieren.
Ethen dient als Modellmolekül für die heterogenkatalytische Hydrierung von Verbindungen mit Doppelbindung, da nur ein Produkt entsteht. Durch die Messung von Konzentrations-Zeit-Profilen und die Anwendung oberflächenanalytischer Methoden lässt sich die Reaktion detailliert untersuchen.[79]
Sonstige Reaktionen
Bei Hitze und unter Luftabschluss zerfällt Ethen zu Methan und Kohlenstoff.
Mit Dischwefeldichlorid reagiert Ethen zu Senfgas.
Dem belgischen Chemiker César-Mansuète Despretz gelang auf diesem Weg 1822 erstmals die Darstellung von Senfgas. Im Jahr 1916 regten die beiden deutschen Chemiker Wilhelm Lommel und Wilhelm Steinkopf, von deren Initialen der Name Lost abgeleitet ist, seine Verwendung als chemische Waffe an.[80]
Palladiumkomplexe katalysieren die alternierende Copolymerisation von Ethen und Kohlenstoffmonoxid, die sogenannte Polyketonsynthese, die 1984 bei Shell entwickelt wurde.[81] Ethen lässt sich ebenfalls mit Schwefeldioxid copolymerisieren.[82]
Verwendung
Chemische Industrie

Ethen ist in der chemischen Industrie Ausgangsstoff für die Synthese von über 30 % aller Petrochemikalien, es hat das Ethin nach dem Zweiten Weltkrieg weitestgehend verdrängt, weil Ethin teurer herzustellen ist, wohingegen Ethen bei industriellen Prozessen massenhaft anfällt, seitdem Erdöl in großen Mengen zur Verfügung steht.
Die wichtigsten Folgeprodukte des Ethens sind Polyethylen, Ethylendichlorid zur Herstellung von PVC, Ethylenoxid zur Herstellung des Polyester-Vorprodukts Ethylenglycol oder von nichtionischen Tensiden sowie Ethylbenzol zur Herstellung von Polystyrol. Daneben ist Ethen Ausgangsstoff zur Herstellung zahlreicher organischer Verbindungen wie Anthracen, 2-Chlorethanol, Chlorethan, Propanal, Isopren, Vinylacetat, Propansäure, Buten, Styrol, Ethandiol und weiteren Stoffen. Im Wacker-Hoechst-Verfahren wird Ethen großtechnisch unter Verwendung von molekularem Sauerstoff in Acetaldehyd umgesetzt.[83]
| Globaler Ethenverbrauch im Jahr 2000 in%[84] | |
|---|---|
| Folgeprodukt | Prozentualer Anteil |
| HDPE | 26% |
| LDPE | 18% |
| LLDPE | 14% |
| 1,2-Dichlorethan | 12% |
| Ethylenoxid | 12% |
| Ethylbenzol | 7% |
| Sonstige | 9% |
Polyethylen und andere Polyolefine
Ethen lässt sich radikalisch unter hohem Druck oder mit Hilfe von Ziegler-Katalysatoren oder Metallocenen zu Polyethylen polymerisieren.[85]
Es gibt Polyethylen hoher Dichte (High Density Polyethylene, HDPE) und lineares Polyethylen niedriger Dichte (Linear Low Density Polyethylene, LLDPE), die mit Ziegler- oder Metallocenkatalysatoren hergestellt werden. Polyethylen niedriger Dichte (Low Density Polyethylene, LDPE) wird durch radikalische Polymerisation unter hohem Druck hergestellt. Im Jahr 2020 wurden weltweit etwa 102 Millionen Tonnen Polyethylen produziert, davon 33 Millionen Tonnen LDPE. Polyethylen kann für eine Vielzahl von Anwendungen eingesetzt werden, insbesondere für Verpackungen.[86]
Mit anderen Olefinen wie Propylen reagiert Ethen zu Ethylen-Propylen-Copolymeren, unter Zusatz von Dienen zu Ethylen-Propylen-Dien-Kautschuk.[87] Mit Tetrafluorethylen reagiert Ethen zu Ethylen-Tetrafluorethylen-Copolymeren. Mit anderen ungesättigten Verbindungen und Mischungen davon reagiert Ethen zu den entsprechenden Copolymeren wie Ethylen-Vinylacetat-Copolymeren,Ethylen-Chlortrifluorethylen-Copolymeren und vielen weiteren Copolymeren.
Ethylbenzol
Ethylbenzol wird großtechnisch fast ausschließlich durch die säurekatalysierte Reaktion von Benzol mit Ethen hergestellt. Mehr als die Hälfte des Benzolverbrauchs entfällt auf die Herstellung von Ethylbenzol. Die Alkylierung erfolgt entweder in flüssiger Phase mit Aluminiumchlorid oder anderen Friedel-Crafts-Katalysatoren unter Zusatz von Chlorethan als Promotor. Der bei der Alkylierung mit Chlorethan entstehende Chlorwasserstoff dient als Cokatalysator. In der Gasphase wird die Reaktion mit trägergebundener Phosphorsäure, Aluminiumsilikat oder einem Zeolith wie ZSM-5 als Katalysator durchgeführt.[88]
Bei hohen Reaktortemperaturen oder hohen Ethenkonzentrationen kann Ethen unter Bildung von Diethylbenzol mit Ethylbenzol reagieren. Diethylbenzol wird durch Destillation abgetrennt und in den Prozess zurückgeführt, wo es mit Benzol unter Transalkylierung wieder zu Ethylbenzol reagiert.[89] Der größte Teil des Ethylbenzols wird zu Styrol dehydriert, das als Monomer für Polystyrol und andere Polymere verwendet wird. Die Dehydrierung erfolgt in der Dampfphase unter Zugabe von Wasserdampf über einem Eisenoxidkatalysator.[88]
Ethylenoxid

Mit Luft oder Sauerstoff und Silber als Katalysator erfolgt bei einer Temperatur von 220 bis 280 °C und erhöhtem Druck eine Epoxidation zu Ethylenoxid.[91]
Als wichtiger Rohstoff für die chemische Industrie wird Ethylenoxid in einer Vielzahl von Anwendungsgebieten eingesetzt. Durch Umsetzung des Ethylenoxids mit Wasser entstehen Ethylenglycol sowie im geringeren Maße höhere Glycole wie Diethylenglycol, Triethylenglycol sowie Polyethylenglycole.
Mit Ammoniak reagiert es zu Mono-, Di- und Triethanolamin, mit Fettalkoholen zu Fettalkoholethoxylaten. In der Reaktion mit Alkoholen entstehen Ethylenglycolether wie etwa Ethylenglycolmonobutylether. Die direkten Folgeprodukte wiederum werden für die Herstellung einer Vielzahl weitere Produkte eingesetzt.[0]
α-Olefine
Unter Nickelkatalyse lässt sich Ethen zu α-Olefinen mit einer breiten Molekulargewichtsverteilung oligomerisieren.
Die C4- bis C8-Olefine werden für die Herstellung von linearem Polyethylen niederer Dichte verwendet, die Fraktion der C12- bis C18-Olefine wird nach Hydroformylierung und Hydrierung in Fettalkohole mit teilweiser Monomethylverzweigung überführt, die als Rohstoffe für die Herstellung von Tensiden dienen. Höhermolekulare Olefine werden zu innenständigen Olefinen isomerisiert und durch Ethenolyse wieder in kurzkettige Olefine überführt, wobei ein Gemisch aus α-Olefinen mit ungerader und gerader Kohlenstoffkettenlänge entsteht. Diese Reaktionen werden großtechnisch im Shell Higher Olefin Process angewandt.[92]
Fettalkohole
Durch die Reaktion mit Triethylaluminium oligomerisiert Ethen in einer Ziegler-Synthese zu einem Trialkylaluminium, das in einem weiteren Schritt zu Ziegler-Alkoholen oxidiert und hydrolisiert werden kann.
Ziegler-Alkohole dienen als naturidentische Fettalkohole zur Herstellung von Tensiden. Die Fettalkohole können durch Ethoxylierung mit Ethylenoxid zu nichtionischen Tensiden umgesetzt werden. Die Alkoholethoxylate mit kurzer Ethoxylatkette werden durch Sulfatierung mit Schwefeltrioxid und Neutralisation mit Natronlauge zu Alkylethersulfaten umgesetzt.
Bei der Herstellung dieser Stoffe entsteht 1,4-Dioxan, das auch in den daraus hergestellten Produkten enthalten ist. Deutschland beabsichtigt, der Europäischen Chemikalienagentur (ECHA) einen Vorschlag zur Beschränkung dieser Tenside vorzulegen.[93] In den Vereinigten Staaten haben Bundesstaaten wie New York den 1,4-Dioxangehalt in Tensiden auf 1 ppm beschränkt.[94]
Acetaldehyd
Im Wacker-Hoechst-Verfahren wird Ethen unter Palladium-Katalyse zu Acetaldehyd oxidiert. Der Sauerstoff der Aldehydfunktion stammt dabei aus dem eingesetzten Wasser. Die Reaktionsfolge wird durch den folgenden katalytischen Zyklus dargestellt:[83]
Bis zum Aufkommen des Monsanto- und Cativa-Prozesses war die Ethenoxidation nach dem Wacker-Hoechst-Verfahren die großindustrielle Route zur Herstellung von Essigsäure. Die Produktionskapazität für Essigsäure nach diesem Verfahren betrug 2009 noch etwa 2 Millionen Tonnen pro Jahr.[95]
1,2-Dichlorethan
Ethen reagiert mit Chlor zu 1,2-Dichlorethan in einer Additionsreaktion.
Alternativ kann 1,2-Dichlorethan durch Oxychlorierung von Ethen mittels Chlorwasserstoff (HCl) und Sauerstoff (O2) hergestellt werden. Der bei der thermischen Spaltung von 1,2-Dichlorethan entstehende Chlorwasserstoff wird in den Prozess zurückgeführt. Als Katalysator wird Kupfer(II)-chlorid verwendet, die Reaktion findet bei Temperaturen von etwa 225 °C und einem Druck von 2 bis 4 bar statt. Da bei der Herstellung von Vinylchlorid Chlorwasserstoff als Koppelprodukt anfällt, sind Chlorierungs- und Oxychlorierungsanlagen häufig integriert. Ein Teil des 1,2-Dichlorethans wird durch Chlorierung und ein anderer Teil durch Oxychlorierung hergestellt.[96] Die einzelnen Reaktionsschritte sind:
Dichlorethan wird zur Herstellung von Vinylchlorid verwendet sowie als Abbeizmittel. Früher wurde es zusammen mit 1,2-Dibromethan als Scavenger in mit Tetraethylblei versetzten Kraftstoffen verwendet, um Bleioxidrückstände im Motorraum in flüchtige Bleichloride zu überführen. Weiterhin dient es als Lösungsmittel. Vinylchlorid wird zu Polyvinylchlorid (PVC) polymerisiert.[96]
Ethanol
Durch Umsetzen mit Schwefelsäure entsteht ein Schwefelsäurehalbester, der durch Hydrolyse in Ethanol umgesetzt werden kann. Diese Syntheseroute zum Industriealkohol wurde durch die Phosphorsäure katalysierte Umsetzung mit Wasser ersetzt.[97]
Fruchtreifung

Ethen wird zum Reifen unreifer klimakterischer Früchte wie Äpfel, Bananen und Tomaten sowie zur Induktion der Blütenbildung benutzt, entweder durch Begasung in geschlossenen Gewächshäusern, Obstlagern oder im Freien über Wirkstoffe, die Ethen in der Pflanzenzelle freisetzen, wie etwa Ethephon oder Etacelasil. Ethen wird für das Degreening von Zitrusfrüchten eingesetzt, Nebeneffekt ist das Weichwerden der Schale, was diese für Pilzwachstum anfällig macht.[98] Äpfel, Cherimoya, Physalis, Maracujas und Sapotengewächse setzen besonders viel Ethen frei.[99] Bei verschiedenen Apfelsorten wurden je nach Lagerzeit bei kühler Lagerung eine Freisetzung zwischen etwa einem und zehn Mikrolitern Ethen pro Kilogramm Äpfel und Stunde gemessen.[100]
Sonstige Verwendung
Ethen ist des Weiteren ein Brenngas und wird für Hochgeschwindigkeits-Flammspritzen verwendet. Außerdem wird es zur Herstellung von Schädlingsbekämpfungsmitteln und chemischer Waffen wie dem Senfgas (2,2-Dichlordiethylsulfid) verwendet. Während des Zweiten Weltkrieges wurde Ethengas von dem Spezialtrupp Taifun beim Angriff auf Festungen experimentell eingesetzt.[101]
Biologische Bedeutung
Biosynthese

Enzyme: 1. SAM Synthetase, 2. ACC Synthetase, 3 ACC Oxidase, 4. ACC N-Malonyl-Transferase, 5. MTA Nucleosidase, 6. MTR Kinase, 7. Transaminase, S. Spontane Reaktion.
Abkürzungen: ATP: Adenosintriphosphat. ADP: Adenosindiphosphat. ACC: 1-Aminocyclopropan-1-carbonsäure. HCN: Cyanwasserstoff. MTA: 5´-Methylthioadenosin. MTR: 5´-Methylthioribose. PPi: Diphosphat. Pi: Phosphat. SAM: S-Adenosyl-L-Methionin
Es wird von Pflanzen ausgehend von der Aminosäure L-Methionin schrittweise enzymatisch synthetisiert, teilweise stimuliert durch das Phytohormon Auxin.[103] Dabei entsteht in einem ersten Schritt durch die Kopplung an Adenosin das S-Adenosylmethionin (SAM). Aus dem Folgeprodukt 1-Aminocyclopropancarbonsäure (ACC) wird durch die ACC-Oxidase Ethen freigesetzt.[102] Die Bildung der ACC-Oxidase wird durch Ethen selbst stimuliert, wodurch wie bei einer autokatalytischen Reaktion in benachbarten Zellen die Ethenbildung vorangetrieben wird. Als gasförmiger Stoff findet sich Ethen dabei vor allem in den Räumen zwischen den Zellen, den Interzellularen. Es diffundiert ständig aus der Pflanze, so dass Abbaureaktionen keine Bedeutung haben.[102]
Das zweite Reaktionsprodukt der ACC-Synthase-Reaktion, 5′-Methylthioadenosin (MTA), wird über den Yang-Zyklus wieder in das Ausgangsprodukt L-Methionin umgewandelt. Pflanzen, die ständig L-Methionin zur Bildung von Ethen benötigen, gewinnen es durch diesen Kreisprozess zurück, ohne es energieaufwändig neu synthetisieren zu müssen. Dies ist etwa bei Früchten nach der Trennung von der Mutterpflanze von Belang.[102] Ein bedeutender Ansatzpunkt der natürlichen und künstlichen Regulierung der Ethenbiosynthese ist die ACC-Synthase.[22] Synthetische ACC-Synthase-Hemmer wie 1-Aminoethoxyvinylglycin und Aminooxyessigsäure hemmen effektiv die Wirkung endogenen Ethens.
Pflanzenphysiologische Wirkung
Ethen ist ein Pflanzenhormon und reguliert als solches zahlreiche Wachstums- und Entwicklungsprozesse, darunter Zellteilung und -wachstum, Gewebedifferenzierung, Samenkeimung, Wurzelhaarbildung, Blüte, Fruchtreifung und Geschlechtsdeterminierung.[22] Auch ist es beteiligt beim Abwurf der Blätter im Herbst sowie das Absterben von Pflanzenteilen und der Alterung.[104] Es spielt eine wichtige Rolle bei der Reaktion der Pflanzen auf biotischen und abiotischen Stress, ausgelöst zum Beispiel durch Infektionen mit Krankheitserregern, Salzgehalt, Trockenheit, Staunässe, Sauerstoffmangel, Nährstoffmangel, Verletzung, Bodenverdichtung, Kälte und Hitze.[22][105] Bereits in Konzentrationen von nur 0,1 Parts per million in der Luft hat es Auswirkungen auf das Pflanzenwachstum und die Entwicklung.[104][106]
Im Allgemeinen hemmt Ethen das Wachstum von terrestrischen Pflanzen. Bei semiaquatischen Pflanzen wie Reis (Oryza sativa) dagegen beobachtet man eine Förderung des Sprosswachstums. Viele klimakterische Früchte wie Äpfel, Bananen und Tomaten zeigen im späten grünen Stadium einen steilen Anstieg der Ethylensynthese. Als Folge werden Chlorophylle ab- und andere Pigmente aufgebaut. Die typische Farbe der Fruchtwand entsteht. Die Aktivität etlicher für den Reifeprozess benötigter Enzyme nimmt zu. Stärke und organische Säuren, in einzelnen Fällen (z. B. bei der Avocadofrucht) auch Öle, werden zu Zuckern metabolisiert. Pektine, die den hauptsächlichen Bestandteil der Mittellamelle ausmachen, werden abgebaut. Die Früchte werden weich. Die Umsetzungen sind mit einer intensiven Zellatmung und einem hohen Sauerstoffverbrauch verbunden. In Trenngeweben ist der Ethengehalt besonders hoch was schließlich die Abszission der Früchte zur Folge hat. Reifende Früchte setzen Ethen frei und stimulieren damit in der Nähe befindliche spätreife Früchte zu einer frühen Reife. Da es für die Lagerung von Früchten wünschenswert ist, die Bildung oder die Verbreitung von Ethen zu verhindern, werden in der Obstwirtschaft Früchte bei Unterdruck gelagert, um frei werdendes Ethen zu entfernen.[107]
Wirkmechanismus

Ein Großteil der Erkenntnisse zum physiologischen Wirkungsmechanismus des Ethens wurde an der Modellpflanze Acker-Schmalwand (Arabidopsis thaliana) gewonnen. Ethen entfaltet seine Wirkung als Inversagonist an Ethylenrezeptoren, die sich auf der Membran des endoplasmatischen Retikulums und des Golgiapparats befinden und dort als Homo- und Hetero-Dimere in Clustern vorkommen.[22] Es komplexiert mit seiner π-Bindung hochaffin über den Cofaktor Kupfer(I) an die in der Transmembrandomäne befindliche Ligandbindungsstelle der Rezeptoren.[108] Neben dem vorherrschenden Signaltransduktionspfad über die Serin/Threonin-Kinase CTR1 gibt es auch alternative CTR1-unabhängige Pfade.[105] Ethen führt zur Deaktivierung der konstitutiv aktiven Rezeptoren, indem CTR1 deaktiviert wird, was wiederum zur Dephosphorylierung des Proteins EIN2 führt. Infolgedessen wird der C-terminale Teil von EIN2 proteolytisch abgespalten und in den Zellkern verlagert. Dort stabilisiert es direkt oder indirekt die Transkriptionsfaktoren EIN3/EIL1/2, die die Transkription von hunderten primären und sekundären Ethenantwortgenen aktivieren.[109][106][105] Das erste identifizierte Zielgen dieser Proteine wurde als Ethen-Response-Faktor 1 (ERF1) beschrieben. Dieser Faktor steuert wiederum mehrere Gene, sodass bei der Wirkung von Ethen auf dieses System immer eine ganze Reihe von genetischen Aktivitäten ausgelöst wird.[110] Bei der Fruchtreifung müssen etwa verschiedene Enzyme zur Erweichung der Zellwand gebildet werden, bei der Seneszenz chitin- und celluloseabbauende Enzyme (Chitinasen, Cellulasen). Sehr umfangreich ist das Repertoire beim Pflanzenstress, also der durch Ethen ausgelösten Reaktion auf Schädlinge und Verwundungen. Produziert werden in dieser Situation unter anderen Chitinasen als Abwehrstoff gegen Insekten, Glucanasen, Proteinase-Inhibitoren, das sind Hemmstoffe für proteinabbauende Enzyme, gegen Pilze, und viele weitere Abwehrstoffe.
Bereits 1901 zeigte Dimitri Neljubov, dass Ethen bei Pflanzen die so genannte „Dreifachantwort“ auslöst. Diese tritt bei keimenden Wurzeln auf, die mit Ethen begast werden. Aufgefallen war der Effekt bei Pflanzen entlang defekter Stadtgasleitungen, die ein ungewöhnliches Wachstum zeigten. Es handelt sich dabei um eine Hemmung des Längenwachstums in Zusammenwirken mit einer Verdickung des Stängels und eine Deaktivierung des Gravitropismus, also des Wachstums in Richtung der Erdanziehungskraft. Diese Wirkung kommt zustande durch eine Umorientierung der Microtubuli, die als Skelettstrukturen die Wachstumsrichtung (Anlagerung von Cellulosefasern) des Keimes vorgeben. Sie werden von einer vertikalen in eine horizontale Orientierung gebracht. Als biologischer Sinn wird die Überwindung von Hindernissen angenommen: Ethen wird während des gesamten Wachstums gebildet und staut sich vor Hindernissen, an diesen kommt es zum Dickenwachstum und somit zu einer größeren Kraftentfaltung durch die Wurzelspitze.[22]
Der Ethen-Signalweg findet sich in der Süßwassergrünalge Spirogyra pratensis, also im aquatischen Vorfahr der sich während des Landgangs spätestens im Ordovizium entwickelnden Landpflanzen. Reguliert wird die Ethenantwort von anderen Hormonen wie Auxinen Brassinosteroiden und Jasmonaten.[106] Ethen diffundiert aufgrund seiner Lipophilie und geringen Molekülgröße leicht durch Biomembranen und wird nicht metabolisiert. ACC wird über das Leitgewebe in der Pflanze auch über größere Strecken zum Wirkort transportiert.
1-Methylcyclopropen, das als Begasungsmittel zur Verlängerung der Haltbarkeit sowohl von Obst als auch Schnittblumen eingesetzt wird, wirkt als Ethylenrezeptor-Agonist und antagonisiert kompetitiv die Ethenwirkung. Auf dieselbe Weise wirken Norbornadien und trans-Cycloocten.[105] Die Wechselwirkung zwischen dem Ethylenrezeptor und EIN2 lässt sich durch das synthetische Octapeptid NOP-1 stören und die Weiterleitung des Ethen-Signals dadurch verzögern. Durch Behandlung mit NOP-1 lässt sich die Fruchtreifung etwa in Tomaten und Äpfeln unterdrücken.[111]
Die zweite Funktion des Ethens bezieht sich auf verschiedene Alterungsprozesse der Pflanze. Dazu gehören sowohl die Reifung von Früchten und die Entwicklung von Blüten als auch der Abwurf von Blättern (Abszission) oder das Absterben von Pflanzenteilen (Seneszenz). Wichtig für diese Funktionen ist die lawinenartige Steigerung der verfügbaren Ethenmenge, die dadurch zustande kommt, dass die Synthese von Ethen durch die Präsenz desselben aktiviert wird. Auf diese Weise reift etwa eine Frucht an allen Stellen zugleich. Die Wirkung bei der Reifung von Früchten wird in der Landwirtschaft ausgenutzt, um unreif geerntete Früchte nachträglich zu Stoffwechselvorgängen zu veranlassen, die die Früchte reifen lassen.[112]
Ebenfalls essentiell ist Ethen als „Alarmstoff“ bei Schädlingsbefall an der Pflanze sowie bei Verwundungen. Gemeinsam mit anderen Stoffen wie der Salicylsäure und Jasmonaten bewirkt das Ethen eine Abgrenzung des betroffenen Bereiches sowie die Bereitstellung von pflanzlichen Giften. Als Gas wirkt Ethen dabei auf benachbarte Pflanzenteile oder Pflanzen als Pheromon und setzt dort die Alarmkaskade in Gang. So kommunizieren Akazien über die Ausscheidung von Ethen an umstehende Akazien Gefahr, wenn sie von Antilopen oder Giraffen beweidet werden.[113]
Genmanipulation
Das Züchten von Pflanzen mit verringerter Ethen-Biosynthese oder veränderter Reizübertragung ist insbesondere in der Zierpflanzenindustrie bereits gängige Praxis.[114] In Tomaten wurde die Unterdrückung der Ethenbildung durch Gegenstrang-Expression der ACC-Synthase oder ACC-Oxidase erreicht. Daneben wurde ein mutierter und damit defekter Ethylenrezeptor in die Pflanze eingebracht.[107]
Sicherheitstechnische Aspekte
Ethen verbrennt an der Luft mit leicht rußender, leuchtender Flamme. Ethen ist hochentzündlich. Ethenbehälter müssen an einem gut belüfteten Ort aufbewahrt werden. Von Zündquellen ist es fernzuhalten und es müssen Maßnahmen gegen elektrostatische Aufladung getroffen werden. In Volumenanteilen von 2,4 bis 32,6 Mol-% in Luft bildet es explosive Gemische.[1] In hoher Konzentration wirkt Ethen narkotisch und reduziert in Luft den zum Atmen nötigen Sauerstoffgehalt.
Im Jahr 2008 kam es durch Reparaturarbeiten an einer Ethenpipeline in Köln-Worringen zum Austritt von Ethen. Das unter hohem Druck stehende Gas entzündete sich und führte zum Brand der Ethenpipeline und eines nahegelegenen Acrylnitriltanks. Das Feuer führte zum größten Feuerwehreinsatz in Deutschland seit dem Zweiten Weltkrieg.[115]
Toxikologie
Nach einer Exposition wird Ethen kaum verstoffwechselt und unverändert ausgeatmet. Bei hoher Exposition kann Ethen im Körper teilweise zu Ethylenoxid umgewandelt werden, einem bekannten Karzinogen. Bei Versuchstieren verursacht Ethylenoxid eine Reihe von bösartigen Tumoren, und auch beim Menschen wurden genotoxische Wirkungen beobachtet. Ethen könnte damit zum Krebsrisiko des Tabakrauchens beitragen.[116] Die Internationale Agentur für Krebsforschung (IARC) ordnete Ethen der Gruppe 3 zu. Dies sind nicht einstufbare oder wahrscheinlich nicht krebsauslösende Stoffe beim Menschen.[117]
Nachweis
Die Doppelbindung des Ethens kann mit Hilfe von Bromwasser nachgewiesen werden, da bei der Reaktion der beiden Stoffe das Brom unter Bildung von 1,2-Dibromethan verbraucht und dadurch das bräunliche Bromwasser entfärbt wird. Der Nachweis ist nicht spezifisch für Ethen und hat nur historische Bedeutung. Zu den Methoden für den Nachweis von Ethen in geringen Mengen, etwa bei der Untersuchung von durch Pflanzen freigesetzte Mengen, gehören die Gaschromatographie, der elektrochemische Nachweis und spektroskopische Methoden.[118] Zu den Prozessüberwachungsinstrumenten gehören Gaschromatographen und Explosimeter, die mit der Messung der Wärmetönung oder mit Infrarot-Messverfahren arbeiten.[56]
Literatur
- Muhammad Arshad, William T. Frankenberger (Hrsg.): Ethylene: Agricultural Sources and Applications. Springer, New York, 2002, ISBN 978-0-306-46666-3.
- Pieter Imhof, Jan Cornelis van der Waal (Hrsg.): Catalytic Process Development for Renewable Materials. Wiley-VCH Verlag, 2013, ISBN 978-3-527-33169-7.
- Ehsan Kianfar, Mahmound Salini: A Review on the Production of Light Olefins from Hydrocarbons Cracking and Methanol Conversion. In: James C. Taylor (Hrsg.): Advances in Chemistry Research. Band 59, Nova Science Publishers, New York, 2020, ISBN 978-1-5361-7112-9.
Einzelnachweise
- ↑ Hochspringen nach: a b c
d e f g
h i Eintrag zu
 Ethen in der GESTIS-Stoffdatenbank
des Institut für Arbeitsschutz der Deutschen Gesetzlichen Unfallversicherung, abgerufen am 19. Januar 2026. (JavaScript erforderlich)
Ethen in der GESTIS-Stoffdatenbank
des Institut für Arbeitsschutz der Deutschen Gesetzlichen Unfallversicherung, abgerufen am 19. Januar 2026. (JavaScript erforderlich)
- ↑ David R. Lide (Hrsg.): CRC Handbook of Chemistry and Physics. 90. Auflage. (Internet-Version: 2010), CRC Press / Taylor and Francis, Boca Raton FL, Permittivity (Dielectric Constant) of Gases, S. 6-188.
- ↑ Eintrag zu
 Ethylene in der Datenbank ECHA CHEM der
Europäischen Chemikalienagentur (ECHA), abgerufen am 19. Januar 2026. Hersteller bzw.
Inverkehrbringer können die harmonisierte Einstufung und Kennzeichnung
Ethylene in der Datenbank ECHA CHEM der
Europäischen Chemikalienagentur (ECHA), abgerufen am 19. Januar 2026. Hersteller bzw.
Inverkehrbringer können die harmonisierte Einstufung und Kennzeichnung
 erweitern.
erweitern.
- ↑ Schweizerische Unfallversicherungsanstalt (Suva):
 Grenzwerte – Aktuelle MAK- und BAT-Werte (Suche nach 74-85-1 bzw. Ethen), abgerufen am 19. Januar 2026.
Grenzwerte – Aktuelle MAK- und BAT-Werte (Suche nach 74-85-1 bzw. Ethen), abgerufen am 19. Januar 2026.
- ↑ W. M. Haynes (Hrsg.): CRC Handbook of Chemistry and Physics. 97. Auflage. (Internet-Version: 2016), CRC Press / Taylor and Francis, Boca Raton FL, Standard Thermodynamic Properties of Chemical Substances, S. 5-19.
- ↑
 Nomenclature of Organic Chemistry.
IUPAC Recommendations and Preferred Names 2013. Chapter P-5 Selecting Preferred IUPAC Names and Constructing Names of Organic Compounds. P-56.4 (PDF-Datei).
Nomenclature of Organic Chemistry.
IUPAC Recommendations and Preferred Names 2013. Chapter P-5 Selecting Preferred IUPAC Names and Constructing Names of Organic Compounds. P-56.4 (PDF-Datei).
- ↑ Frederick B. Abeles, Page W. Morgan, Mikal E. Saltveit, Jr.: Ethylene in Plant Biology. Academic Press, San Diego, 1992, ISBN 0-12-041451-1, S. 1–2.
- ↑ Hochspringen nach: a b Daniel Chamovitz: What A Plant Knows: A Field Guide to Senses. Scientific American, 2012, ISBN 978-0-374-28873-0, S. 29–30.
- ↑ Hochspringen nach: a b Philip Wexler: History of Toxicology and Environmental Health Toxicology in Antiquity. Volume I. Elsevier, Amsterdam, Tokio, 2014, ISBN 978-0-12-800045-8, S. 87–89.
- ↑ Marcus Tullius Cicero, De divinatione 1,115.
- ↑ Winfried R. Pötsch, Annelore Fischer und Wolfgang Müller unter Mitarbeit von Heinz Cassebaum: Lexikon bedeutender Chemiker. Bibliographisches Institut, Leipzig 1988, ISBN 3-323-00185-0, S. 33–34.
- ↑ Appendix, §VIII, S. 474 ff.,
 Experiments and observations relating to the various branches of natural philosophy: with a continuation of the observations on air,
Joseph Priestley, London: printed for J. Johnson, 1779, Band 1.
Experiments and observations relating to the various branches of natural philosophy: with a continuation of the observations on air,
Joseph Priestley, London: printed for J. Johnson, 1779, Band 1.
- ↑ Seth C. Rasmussen: Acetylene and Its Polymers. 150+ Years of History. Springer, ISBN 978-3-319-95488-2, S. 9 f.
(
 eingeschränkte Vorschau in der Google-Buchsuche).
eingeschränkte Vorschau in der Google-Buchsuche).
- ↑ Eintrag zu
 Dichlorethane.
In: Römpp Online. Georg Thieme Verlag, abgerufen am am 19. Januar 2026.
Dichlorethane.
In: Römpp Online. Georg Thieme Verlag, abgerufen am am 19. Januar 2026.
- ↑ P. R. Salvi: Dalton’s Long Journey from Meteorology to the Chemical Atomic Theory. In: Substantia. 7.2, 2023, S. 101–119,
 doi:10.36253/substantia-2126.
doi:10.36253/substantia-2126.
- ↑ M. Simpson: XXVI.—On the synthesis of succinic and pyrotartaric acids. In: J. Chem. Soc. 15, 1862, S. 134–141,
 doi:10.1039/js8621500134.
doi:10.1039/js8621500134.
- ↑ Hochspringen nach: a b H. Orth, I. Kis: Schmerzbekämpfung und Narkose. In: Franz Xaver Sailer, Friedrich Wilhelm Gierhake (Hrsg.): Chirurgie historisch gesehen. Anfang – Entwicklung – Differenzierung. Dustri-Verlag, Deisenhofen bei München 1973, ISBN 3-87185-021-7, S. 14.
- ↑ Arno Benedict Luckhardt: Ethylene as a gas anaesthetic. Preliminary Communication. In: J. Amer. Med. Ass. Band 80, 1932, S. 1440–1442;
 doi:10.1001/jama.1923.02640470018007.
doi:10.1001/jama.1923.02640470018007.
- ↑ H. Orth, I. Kis: Schmerzbekämpfung und Narkose. In: Franz Xaver Sailer, Friedrich Wilhelm Gierhake (Hrsg.): Chirurgie historisch gesehen. Anfang – Entwicklung – Differenzierung. Dustri-Verlag, Deisenhofen bei München 1973, ISBN 3-87185-021-7, S. 26.
- ↑ L. K. Riggs: Anesthetic Properties of the Olefine Hydrocarbons, Ethylene, Propylene, Butylene and Amylene. In:
The Journal of the American Pharmaceutical Association. 14. 5, 1925, S. 380–387,
 doi:10.1002/jps.3080140505.
doi:10.1002/jps.3080140505.
- ↑ Erston V. Miller: The Story of Ethylene. In: The Scientific Monthly. 65.4, 1947, S. 335–342,
JSTOR:
 19231
19231
- ↑ Hochspringen nach: a b c
d e f A. Bakshi, J. M. Shemansky, C. Chang, B. M. Binder:
History of Research on the Plant Hormone Ethylene. In: Journal of Plant Growth Regulation. 34.4, 2015, S. 809–827,
 doi:10.1007/s00344-015-9522-9.
doi:10.1007/s00344-015-9522-9.
- ↑ Hochspringen nach: a b Pieter Imhof, Jan Cornelis van der Waal (Hrsg.): Catalytic Process Development for Renewable Materials. Wiley-VCH Verlag, 2013, ISBN 978-3-527-33169-7, S. 25–27.
- ↑ T.J. Hutley, M. Ouederni: Polyolefins—The History and Economic Impact. In: M. Al-Ali AlMa'adeed, I. Krupa (Hrsg.):
Polyolefin Compounds and Materials. Springer Series on Polymer and Composite Materials. Springer, Cham, 2016,
 doi:10.1007/978-3-319-25982-6_2, S. 13–50.
doi:10.1007/978-3-319-25982-6_2, S. 13–50.
- ↑ Karl Ziegler, Erhard Holzkamp, Heinz Breil, Heinz Martin:
Polymerisation von Äthylen und anderen Olefinen. In: Angewandte Chemie . 67, 1955, S. 426–426,
 doi:10.1002/ange.19550671610.
doi:10.1002/ange.19550671610.
- ↑ K. F. Steinberger: Rohstoffe für Acetylen und Aethylen. In: Angewandte Chemie. 19.8, 1947, S. 211–214,
 doi:10.1002/ange.19470190802.
doi:10.1002/ange.19470190802.
- ↑ Friedrich Asinger: Chemie und Technologie der Monoolefine. Akademie-Verlag, Berlin, 1957, S. 54.
- ↑
 Sasol gets stake in German pipeline. In: news24.com. 30. September 2002, abgerufen am 19. Januar 2026 (englisch).
Sasol gets stake in German pipeline. In: news24.com. 30. September 2002, abgerufen am 19. Januar 2026 (englisch).
- ↑ Oliver Konze: Pipeline zwei Wochen lang befüllt. In: donaukurier.de.
- ↑ D. Dronia: Die Ethylen-Pipeline Süd – Ein besonderes Infrastrukturprojekt. In: S. Berg, J. Bofinger, R. Schulz:
370 Kilometer Archäologie – Ausgrabungen an der Ethylen Pipelinetrasse in Bayern, Baden-Württemberg und Rheinland-Pfalz. University Library Heidelberg, 2019,
 doi:10.11588/PROPYLAEUM.395, S. 15–21.
doi:10.11588/PROPYLAEUM.395, S. 15–21.
- ↑ Alexander H. Tullo: Petrochemical makers look ahead to an uncertain decade. In: cendev.acs.org. 16. März 2020, (englisch).
- ↑ Manfred Baerns u. a.: Technische Chemie. 2. Auflage. Wiley-VCH Verlag GmbH & Co. KGaA, Weinheim, Germany 2013, ISBN 978-3-527-33072-0, S. 551.
- ↑
 Ethylen: Produktion in Deutschland bis 2022 – Statista. In: de.statista.com.
Abgerufen am am 19. Januar 2026.
Ethylen: Produktion in Deutschland bis 2022 – Statista. In: de.statista.com.
Abgerufen am am 19. Januar 2026.
- ↑
 Ethylene Market Research Report, Share & Forecast by 2023 - 2032. In: polarismarketresearch.com.
Abgerufen am am 19. Januar 2026 (englisch).
Ethylene Market Research Report, Share & Forecast by 2023 - 2032. In: polarismarketresearch.com.
Abgerufen am am 19. Januar 2026 (englisch).
- ↑
 Dow’s Hulgan oversees expansion of ‘crown jewel’ TX-9 cracker.
In: bicmagazine.com. 7. Februar 2020, abgerufen am am 19. Januar 2026 (englisch).
Dow’s Hulgan oversees expansion of ‘crown jewel’ TX-9 cracker.
In: bicmagazine.com. 7. Februar 2020, abgerufen am am 19. Januar 2026 (englisch).
- ↑ Kristen Hays: Commodities 2023: Europe set for greater ethylene import attention amid energy volatility. In: spglobal.com. 5. Dezember 2022 (englisch).
- ↑ Hochspringen nach: a b c
B. Franco u. a.: Ethylene industrial emitters seen from space. In: Nature Communications. 13.1, 2022,
 doi:10.1038/s41467-022-34098-8.
doi:10.1038/s41467-022-34098-8.
- ↑ Muhammad Arshad, William T. Frankenberger (Hrsg.): Ethylene: Agricultural Sources and Applications. Springer, New York, 2002, ISBN 978-0-306-46666-3, S. 141–145.
- ↑ P. N. Romani u. a.: Temporally varying ethylene emission on Jupiter. In:
Icarus. 198.2, 2008, S. 420–434,
 doi:10.1016/j.icarus.2008.05.027.
doi:10.1016/j.icarus.2008.05.027.
- ↑ B. E. Hesman u. a.: Eliusive Ethylene detected in Saturn´s northern Storm Region. In:
The Astrophysical Journal. 760.1, S. 24,
 NASA.gov. (PDF)
NASA.gov. (PDF)
- ↑ B. Schulz u. a.: Detection of C2H4 in Neptune from ISO/PHT-S observations. In: Astronomy and Astrophysics. 31.1, 1999, S. 1180–1184.
- ↑ Michael E. Brown, E. L. Schaller, G. A. Blake: Irridiation Products on dwarf Planet Makemake. In: The Astronomical Journal. 149.3, 2015, S. 105,
 doi:10.1088/0004-6256/149/3/105.
doi:10.1088/0004-6256/149/3/105.
- ↑ Steve Lewandowski: Ethylene – Global. Vortrag auf der Asia Chemical Conference, November 2016.
- ↑ American Fuel & Petrochemical Manufacturers:
 Ethylene: The “World’s Most Important Chemical”. In: afpm.org. 6. September 2017, abgerufen am 19. Januar 2026 (englisch).
Ethylene: The “World’s Most Important Chemical”. In: afpm.org. 6. September 2017, abgerufen am 19. Januar 2026 (englisch).
- ↑
 Global ethylene demand & capacity 2015-2022 – Statista. In: statista.com. 24. März 2023,
abgerufen am am 19. Januar 2026 (englisch).
Global ethylene demand & capacity 2015-2022 – Statista. In: statista.com. 24. März 2023,
abgerufen am am 19. Januar 2026 (englisch).
- ↑ Hochspringen nach: a b Heinz Zimmermann, Roland Walzl: Ethylen. In:
Ullmann’s Encyclopedia of Industrial Chemistry. Wiley-VCH, Weinheim, 2012, S. 470–474,
 doi:10.1002/14356007.a10_045.pub3.
doi:10.1002/14356007.a10_045.pub3.
- ↑ Hochspringen nach: a b Ehsan Kianfar, Mahmound Salini: A Review on the Production of Light Olefins from Hydrocarbons Cracking and Methanol Conversion. In: James C. Taylor (Hrsg.): Advances in Chemistry Research. Band 59, Nova Science Publishers, New York, 2020, ISBN 978-1-5361-7112-9, S. 1–82.
- ↑ N. Rahimi, R. Karimzadeh: Catalytic cracking of hydrocarbons over modified ZSM-5 zeolites to produce light olefins: A review.
In: Applied Catalysis A: General. 398.1–2, 2011, S. 1–17,
 doi:10.1016/j.apcata.2011.03.009.
doi:10.1016/j.apcata.2011.03.009.
- ↑ Alexander H. Tullo:
 The search for greener ethylene. In: cen.acs.org. 15. März 2021, abgerufen am am 19. Januar 2026 (englisch).
The search for greener ethylene. In: cen.acs.org. 15. März 2021, abgerufen am am 19. Januar 2026 (englisch).
- ↑ Hochspringen nach: a b c Paulo Luiz de Andrade Coutinho u. a.: Braskem’s Ethanol to Polyethylene Process Development. In: Pieter Imhof, Jan Cornelis van der Waal (Hrsg.): Catalytic Process Development for Renewable Materials. Wiley‐VCH, 2013, ISBN 978-3-527-33169-7, S. 149–167.
- ↑ Hochspringen nach: a b Heinz Zimmermann, Roland Walzl: Ethylen. In:
Ullmann’s Encyclopedia of Industrial Chemistry. Wiley-VCH, Weinheim, 2012, S. 520–521,
 doi:10.1002/14356007.a10_045.pub3.
doi:10.1002/14356007.a10_045.pub3.
- ↑ M. E. Dry: Fischer-Tropsch synthesis over iron catalysts. In: Catalysis Letters. 7. 1–4, 1990, S. 241–251,
 doi:10.1007/bf00764506.
doi:10.1007/bf00764506.
- ↑ G. Keller: Synthesis of ethylene via oxidative coupling of methane I. Determination of active catalysts. In: Journal of Catalysis. 73.1, 1982, S. 9–19,
 doi:10.1016/0021-9517(82)90075-6.
doi:10.1016/0021-9517(82)90075-6.
- ↑ J. H. Lunsford: Die katalytische oxidative Kupplung von Methan. In: Angewandte Chemie. 107.9, 1995, S. 1059–1070,
 doi:10.1002/ange.19951070905.
doi:10.1002/ange.19951070905.
- ↑ J. Liu u. a.: From fundamentals to chemical engineering on oxidative coupling of methane for ethylene production: A review.
In: Carbon Resources Conversion. 5.1, 2022, S. 1–14,
 doi:10.1016/j.crcon.2021.11.001.
doi:10.1016/j.crcon.2021.11.001.
- ↑ Hochspringen nach: a b Heinz Zimmermann, Roland Walzl: Ethylen. In:
Ullmann’s Encyclopedia of Industrial Chemistry. Wiley-VCH, Weinheim, 2012, S. 522–523,
 doi:10.1002/14356007.a10_045.pub3.
doi:10.1002/14356007.a10_045.pub3.
- ↑ T. D. Shittu, O. B. Ayodele: Catalysis of semihydrogenation of acetylene to ethylene: current trends, challenges, and outlook.
In: Frontiers of Chemical Science and Engineering. 16.1, 2022, S. 1031–1059,
 doi:10.1007/s11705-021-2113-3.
doi:10.1007/s11705-021-2113-3.
- ↑ Hochspringen nach: a b Friedrich Asinger: Chemie und Technologie der Monoolefine. Akademie-Verlag, Berlin, 1957, S. 158–166.
- ↑ Y. Dai u. a.: Recent progress in heterogeneous metal and metal oxide catalysts for direct dehydrogenation of ethane and propane.
In: Chemical Society Reviews. 50.9, 2021, S. 5590–5630,
 doi:10.1039/d0cs01260b.
doi:10.1039/d0cs01260b.
- ↑ S.F.A. Kettle: Die D2h-Charaktertafel und die Elektronenstrukturen von Ethylen und Diboran. In: Symmetrie und Struktur. Vieweg+Teubner, Wiesbaden, 1994,
 doi:10.1007/978-3-663-01207-8_4.
doi:10.1007/978-3-663-01207-8_4.
- ↑ Hochspringen nach: a b c
Heinz Zimmermann, Roland Walzl: Ethylen. In: Ullmann’s Encyclopedia of Industrial Chemistry. Wiley-VCH, Weinheim, 2012, S. 467,
 doi:10.1002/14356007.a10_045.pub3.
doi:10.1002/14356007.a10_045.pub3.
- ↑ Hochspringen nach: a b c
d K. M. Sundaram, M. M. Shreehan, E. F. Olszewski: Ethylene. In: Kirk-Othmer Encyclopedia of Chemical Technology. John Wiley & Sons, 2010, S. 2,
 doi:10.1002/0471238961.0520082519211404.a01.pub3.
doi:10.1002/0471238961.0520082519211404.a01.pub3.
- ↑ Linus Pauling: Die Natur der chemischen Bindung. Verlag Chemie, Weinheim, 1973, rel="nofollow"ISBN 3-527-25217-7, S. 78.
- ↑ Henry Portz: Brand- und Explosionsschutz von A – Z. Vieweg, Wiesbaden, 2005, ISBN 978-3-322-80198-2, S. 349.
- ↑ W. H. Keesom, K. W. Taconis: An x-ray goniometer for the investigation of the crystal structure of solidified gases. In:
Physica. 2, 1935, S. 463–471;
 doi:10.1016/S0031-8914(35)90116-1.
doi:10.1016/S0031-8914(35)90116-1.
- ↑ Noaa Office Of Response, Restoration, Us Gov:
 ETHYLENE – CAMEO Chemicals – NOAA. In: cameochemicals.noaa.gov. Abgerufen am 19. Januar 2026.
ETHYLENE – CAMEO Chemicals – NOAA. In: cameochemicals.noaa.gov. Abgerufen am 19. Januar 2026.
- ↑ Jerry March: Advanced organic chemistry : reactions, mechanisms, and structure. Wiley, New York, 1985, ISBN 0-471-88841-9, S. 657–666.
- ↑ Jerry March: Advanced organic chemistry: reactions, mechanisms, and structure. Wiley, New York, 1985, ISBN 0-471-88841-9, S. 666–670.
- ↑ C. Richard, M. H. Back: Ene reactions of olefins, part II. The addition of ethylene to propylene and to isobutene and the addition of
propylene to propylene. In: International Journal of Chemical Kinetics. 10.4, 1978, S. 389–405,
 doi:10.1002/kin.550100405.
doi:10.1002/kin.550100405.
- ↑ M. J. S. Dewar, S. Olivella, J. J. P. Stewart: Mechanism of the Diels-Alder reaction: reactions of butadiene with ethylene and
cyanoethylenes. In: Journal of the American Chemical Society. 108.19, 1986, S. 5771–5779,
 doi:10.1021/ja00279a018.
doi:10.1021/ja00279a018.
- ↑ Richard A. Love, Thomas F. Koetzle, Graheme J. B. Williams, Lawrence C. Andrews, Robert Bau: Neutron diffraction study of the structure
of Zeise’s salt, KPtCl3(C2H4).H2O. In: Inorganic Chemistry. 14, 1975, S. 2653–2657;
 doi:10.1021/ic50153a012.
doi:10.1021/ic50153a012.
- ↑ K. Fischer, K. Jonas, Günther Wilke:
Tris(ethylene)nickel(0). In: Angewandte Chemie International Edition. 12.7, 1973, S. 565–566,
 doi:10.1002/anie.197305651.
doi:10.1002/anie.197305651.
- ↑ T. W. Bell u. a.: Photochemical isomerization of metal ethene to metal vinyl hydride complexes: a matrix-isolation and solution NMR study.
In: Journal of the American Chemical Society. 112.25, 1990, S. 9212–9226,
 doi:10.1021/ja00181a025.
doi:10.1021/ja00181a025.
- ↑ R. Franke, D. Selent, A. Börner: Applied Hydroformylation. In: Chemical Reviews. 112.11, 2012, S. 5675–5732,
 doi:10.1021/cr3001803.
doi:10.1021/cr3001803.
- ↑ Richard F. Heck, David S. Breslow: The Reaction of Cobalt Hydrotetracarbonyl with Olefins. In:
Journal of the American Chemical Society. 83, 1961, S. 4023–4027,
 doi:10.1021/ja01480a017.
doi:10.1021/ja01480a017.
- ↑ R. J. McKinney, D. Christopher Roe: The mechanism of nickel-catalyzed ethylene hydrocyanation. Reductive elimination by an
associative process. In: Journal of the American Chemical Society. 108.17, 1986, S. 5167–5173,
 doi:10.1021/ja00277a022.
doi:10.1021/ja00277a022.
- ↑ Raymond Friedman: Principles of Fire Protection. Chemistry and Physics. Jones and Bartlett Publishers, Boston, Toronto, London, Singapore, 2009, ISBN 978-0-7637-6070-0, S. 40.
- ↑ D. Weixin u. a.: Ethylene Fueled Scramjet Combustion Experiments. In: Modern Applied Science. 7.5, 2013,
 doi:10.5539/mas.v7n5p51.
doi:10.5539/mas.v7n5p51.
- ↑ P. S. Cremer, Gábor A. Somorjai: Surface science and catalysis of ethylene hydrogenation. In:
Journal of the Chemical Society, Faraday Transactions. 91.20, 1995, S. 3671,
 doi:10.1039/ft9959103671.
doi:10.1039/ft9959103671.
- ↑ Markus Schnedlitz: Chemische Kampfstoffe: Geschichte, Eigenschaften, Wirkung. GRIN Verlag, 2008, ISBN 978-3-640-23360-1, S. 30.
- ↑ Eite Drent, Peter H. M. Budzelaar: Palladium-catalyzed alternating copolymerization of alkenes and carbon monoxide. In: Chemical Reviews. 96.2, 1996, S. 663–682.
- ↑ P. Colombo, J. Fontana, M. Steinberg: Radiation‐induced copolymerization of ethylene and sulfur dioxide in the liquid and gas phases.
In: Journal of Polymer Science. Part A-1: Polymer Chemistry. 6.12, 1968, S. 3201–3215,
 doi:10.1002/pol.1968.150061201.
doi:10.1002/pol.1968.150061201.
- ↑ Hochspringen nach: a b John A. Keith, Patrick M. Henry: Zum Mechanismus der Wacker-Reaktion:
zwei Hydroxypalladierungen! In: Angewandte Chemie. 121, 2009, S. 9200–9212,
 doi:10.1002/ange.200902194.
doi:10.1002/ange.200902194.
- ↑ Heinz Zimmermann, Roland Walzl: Ethylen. In: Ullmann’s Encyclopedia of Industrial Chemistry. Wiley-VCH, Weinheim, 2012, S. 525,
 doi:10.1002/14356007.a10_045.pub3.
doi:10.1002/14356007.a10_045.pub3.
- ↑ Karl Ziegler - Consequences and development of an invention. (PDF; 633 kB) Abgerufen am am 19. Januar 2026.
- ↑ R. Narayana, C. Mohana, A. Kumar: Analytical characterization of erucamide degradants by mass spectrometry. In:
Polymer Degradation and Stability. 200, 2020, S. 109956,
 doi:10.1016/j.polymdegradstab.2022.109956.
doi:10.1016/j.polymdegradstab.2022.109956.
- ↑ Heike Kloppenburg, Thomas Groß, Martin Mezger, Claus Wrana: Das elastische Jahrhundert. Synthesekautschuke. In:
Chemie in unserer Zeit. 43, 2009, S. 392–406;
 doi:10.1002/ciuz.200600515.
doi:10.1002/ciuz.200600515.
- ↑ Hochspringen nach: a b Klaus Weissermel, Hans-Jürgen Arpe: Industrial Organic Chemistry. 3. Auflage. VCH, Weinheim 1997, ISBN 3-527-28838-4, S. 335–339.
- ↑ W. L. Luyben: Design and control of the ethyl benzene process. In: AIChE Journal. 57.3, 2011, S. 655–670,
 doi:10.1002/aic.12289.
doi:10.1002/aic.12289.
- ↑ Hochspringen nach: a b IARC Monographs on the Evaluation of Carcinogenic Risks to Humans: 1,3-Butadiene, Ethylene Oxide and Vinyl Halides (Vinyl Fluoride, Vinyl Chloride and Vinyl Bromide). Bd. 97, International Agency for Research on Cancer, Lyon, 2008, ISBN 978-92-832-1297-3, S. 185–287.<& S. 185–287.
- ↑ T. Pu u. a.: Overview of Selective Oxidation of Ethylene to Ethylene Oxide by Ag Catalysts. In: ACS Catalysis. 9.12, 2019, S. 10727–10750,
 doi:10.1021/acscatal.9b03443.
doi:10.1021/acscatal.9b03443.
- ↑ Wilhelm Keim: Oligomerisierung von Ethen zu α-Olefinen: Erfindung und Entwicklung des Shell-Higher-Olefin-Prozesses (SHOP). In:
Angewandte Chemie. 125, 2013, S. 12722–12726,
 doi:10.1002/ange.201305308.
doi:10.1002/ange.201305308.
- ↑
 Registry of restriction intentions until outcome - ECHA. In: echa.europa.eu.
Abgerufen am am 19. Januar 2026 (englisch).
Registry of restriction intentions until outcome - ECHA. In: echa.europa.eu.
Abgerufen am am 19. Januar 2026 (englisch).
- ↑ Department of Environmental Conservation:
 1,4-Dioxane Limits For Household Cleansing, Personal Care, And Cosmetic Products - NYDEC. In:
dec.ny.gov. 31. Dezember 2022, abgerufen am am 19. Januar 2026 (englisch).
1,4-Dioxane Limits For Household Cleansing, Personal Care, And Cosmetic Products - NYDEC. In:
dec.ny.gov. 31. Dezember 2022, abgerufen am am 19. Januar 2026 (englisch).
- ↑ Reinhard Jira: Acetaldehyd aus Ethylen – ein Rückblick auf die Entdeckung des Wacker-Verfahrens. In: Angewandte Chemie. 121, 2009, S. 9196–9199,
 doi:10.1002/ange.200903992.
doi:10.1002/ange.200903992.
- ↑ Hochspringen nach: a b Harold Witcoff: Industrial organic chemicals. John Wiley & Sons, Hoboken, 2004, ISBN 0-471-44385-9, S. 119–121.
- ↑ Harold Witcoff: Industrial organic chemicals. John Wiley & Sons, Hoboken, 2004, ISBN 0-471-44385-9, S. 135–137.
- ↑ J. Morales u. a.: Impact of ethylene degreening treatment on sensory properties and consumer response to citrus fruits. In:
Food Research International. 127, 2020, S. 108641,
 doi:10.1016/j.foodres.2019.108641.
doi:10.1016/j.foodres.2019.108641.
- ↑ Stephan Pelzl:
 Ethen sorgt für Reife-Effekt bei Obst und Gemüse. In: experto.de. 5. Februar 2009,
abgerufen am am 19. Januar 2026.
Ethen sorgt für Reife-Effekt bei Obst und Gemüse. In: experto.de. 5. Februar 2009,
abgerufen am am 19. Januar 2026.
- ↑ J. Goliáš, P. Mýlová, A, Němcová: A comparison of apple cultivars regarding ethylene production and physico-chemical
changes during cold storage. In: Horticultural Science. 35.4, 2008, S. 137–144,
 doi:10.17221/653-hortsci.
doi:10.17221/653-hortsci.
- ↑ Bernhard R. Kroener, Rolf-Dieter Müller, Hans Umbreit: Organization und Mobilization in the German Sphere of Power. Teilband 2: War Administration, Economy, and Manpower Resources 1942–1944/45. In: Germany and the Second World War. Band 5/2, Clarendon Press, Oxford, 2003, ISBN 0-19-820873-1, S. 764.
- ↑ Hochspringen nach: a b c d Joachim W. Kadereit, Christian Körner, Peter Nick, Uwe Sonnewald: Strasburger – Lehrbuch der Pflanzenwissenschaften. 38. Auflage, Springer, Berlin, 2021, ISBN 978-3-662-61942-1, S. 411–412.
- ↑ Shang Fa Yang: Biosynthesis and Action of Ethylene. In: HortScience. 20.1, S. 41–45,
 doi:10.21273/hortsci.20.1.41.
doi:10.21273/hortsci.20.1.41.
- ↑ Hochspringen nach: a b T. I. Zarembinski, A. Theologis: Ethylene biosynthesis
and action: a case of conservation. In: Plant Molecular Biology. 26.5, 1994, S. 1579–1597,
 doi:10.1007/bf00016491.
doi:10.1007/bf00016491.
- ↑ Hochspringen nach: a b c
d Binder BM: Ethylene signaling in plants. In: J Biol Chem.
295. Jahrgang, Nr. 22, 2020, S. 7710–7725,
doi:
 10.1074/jbc.REV120.010854,
10.1074/jbc.REV120.010854,
 PMID 32332098,
PMID 32332098,
 PMC 7261785 (freier Volltext) – (englisch).
PMC 7261785 (freier Volltext) – (englisch).
- ↑ Hochspringen nach: a b c Ju C,
Chang C: Mechanistic Insights in Ethylene Perception and Signal Transduction. In: Plant Physiol.
169. Jahrgang, Nr. 1, 2015, S. 85–95,
doi:
 10.1104/pp.15.00845,
10.1104/pp.15.00845,
 PMID 26246449,
PMID 26246449,
 PMC 4577421 (freier Volltext) – (englisch).
PMC 4577421 (freier Volltext) – (englisch).
- ↑ Hochspringen nach: a b Bleecker AB, Kende H: Ethylene: a gaseous signal molecule in plants. In: Annu Rev Cell Dev Biol. 16. Jahrgang, 2000,
S. 1–18,
doi:
 10.1146/annurev.cellbio.16.1.1,
10.1146/annurev.cellbio.16.1.1,
 PMID 11031228 (englisch).
PMID 11031228 (englisch).
- ↑ Azhar BJ, Abbas S, Aman S et al.: Basis for high-affinity ethylene binding
by the ethylene receptor ETR1 of Arabidopsis. In: Proc Natl Acad Sci U S A. 120. Jahrgang,
Nr. 23, 2023, S. e2215195120,
doi:
 10.1073/pnas.2215195120,
10.1073/pnas.2215195120,
 PMID 37253004,
PMID 37253004,
 PMC 10266040 (freier Volltext) – (englisch).
PMC 10266040 (freier Volltext) – (englisch).
- ↑ Berleth M, Berleth N, Minges A et al.: Molecular Analysis of Protein-Protein
Interactions in the Ethylene Pathway in the Different Ethylene Receptor Subfamilies. In: Front Plant Sci. 10. Jahrgang, 2019,
S. 726,
doi:
 10.3389/fpls.2019.00726,
10.3389/fpls.2019.00726,
 PMID 31231408,
PMID 31231408,
 PMC 6566107 (freier Volltext) – (englisch).
PMC 6566107 (freier Volltext) – (englisch).
- ↑ Peter J. Davies: Plant Hormones. Biosynthesis, Signal Transduction, Action! Kluwer Academic Publishers, Dordrecht, Boston, London, 2004, ISBN 1-4020-2684-6, S. 358–359.
- ↑ Hoppen C, Müller L, Albrecht AC, Groth G: The NOP-1 peptide derived
from the central regulator of ethylene signaling EIN2 delays floral senescence in cut flowers. In: Sci Rep. 9. Jahrgang,
Nr. 1, 2019, S. 1287,
doi:
 10.1038/s41598-018-37571-x,
10.1038/s41598-018-37571-x,
 PMID 30718569,
PMID 30718569,
 PMC 6361973 (freier Volltext) – (englisch).
PMC 6361973 (freier Volltext) – (englisch).
- ↑ Peter J. Davies: Plant Hormones. Biosynthesis, Signal Transduction, Action! Kluwer Academic Publishers, Dordrecht, Boston, London, 2004, ISBN 1-4020-2684-6, S. 561–581.
- ↑ Sylvia Hughes:
 Antelope activate the acacia's alarm system. In: New Scientist www.newscientist.com.
New Scientist Ltd., abgerufen am 19. Januar 2026 (amerikanisches Englisch).
Antelope activate the acacia's alarm system. In: New Scientist www.newscientist.com.
New Scientist Ltd., abgerufen am 19. Januar 2026 (amerikanisches Englisch).
- ↑ Shibuya K: Molecular aspects of flower senescence and strategies to improve flower longevity. In: Breed Sci. 68. Jahrgang, Nr. 1, 2018, S. 99–108,
doi:
 10.1270/jsbbs.17081,
10.1270/jsbbs.17081,
 PMID 29681752,
PMID 29681752,
 PMC 5903976 (freier Volltext) – (englisch).
PMC 5903976 (freier Volltext) – (englisch).
- ↑ Frank Gerstenberg:
 Masseneinsatz im Pulverfass. In: stern.de. 18. März 2008, abgerufen am am 19. Januar 2026.
Masseneinsatz im Pulverfass. In: stern.de. 18. März 2008, abgerufen am am 19. Januar 2026.
- ↑ H. M. Bolt: Ethylen [BAT Value Documentation in German language, 1994]. In: The MAK‐Collection for Occupational Health and Safety: Annual Thresholds and Classifications for the Workplace. Wiley, 2002, S. 1–8.
- ↑ IARC:
 Agents Classified
by the IARC Monographs, Volumes 1–135 – IARC Monographs on the Identification of Carcinogenic Hazards to Humans. In: monographs.iarc.who.int. Abgerufen am 19. Januar 2026 (englisch).
Agents Classified
by the IARC Monographs, Volumes 1–135 – IARC Monographs on the Identification of Carcinogenic Hazards to Humans. In: monographs.iarc.who.int. Abgerufen am 19. Januar 2026 (englisch).
- ↑ S. M. Cristescu u. a.: Current methods for detecting ethylene in plants. In: Annals of Botany. 111.3, 2012, S. 347–360,
 doi:10.1093/aob/mcs259.
doi:10.1093/aob/mcs259.


© biancahoegel.de
Datum der letzten Änderung: Jena, den: 28.05. 2026










.svg.png)
.svg.png)








